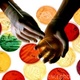
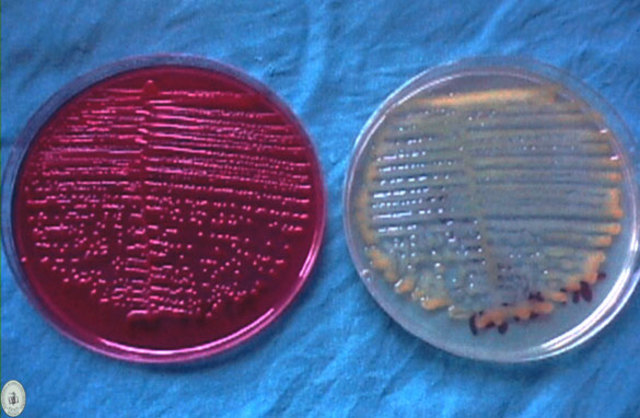
PERIODO DE LA FISIOLOGÍA MICROBIANA (1910-1940)

-
Este periodo se inicia desde los 3 a 2.5 millones de años A.C con la evolucióndel genero homo. Al desarrollarse las primeras prácticas agrícolas y elprocesamiento empírico de los alimentos (10000-7000 A.C) el hombre iniciainconscientemente su relación eterna con los microorganismos. Fueron lossumerios, babilonios y, más exquisitamente, los egipcios los que emplearondirectamente a los microorganismos al desarrollar la fabricación del pan y lacerveza.
-
Fracastoro sugiere que organismo invisibles eran loscausantes de las enfermedades.
-
Enfermedades son causadas por M.O.S transmitidos de una persona a otra
-
Hooke describe observaciones microscópicas de hongos.
-
PERIODO DE LOS CULTIVOS
-
Francesco Redi demostró que los gusanos encontrados en la carne podrida eran las larvas que provenían de los huevos que previamente habían depositado en la carne las moscas y no el producto de la generación espontánea.
-
Anthony Van Leeuwenhoek publica en la revista
“
PHILOSOPHICAL TRANSACTIONS OF THE ROYAL SOCIETY”
, su primerarticuló sobre observaciones microscópicas y la primera persona en describirlos microorganismos en detalle, a los cuales denomino
animáculos. -
Después que las publicaciones de
Leewenhoek
demostraron la existencia delos microorganismos fue necesario, sin embargo, esperar cerca de 200 añospara que la microbiología tenga un avance rápido. Esto fue debidoprincipalmente al predominio en aquella época de la Teoría de la Generaciónespontánea. -
Jhon Needham hirvió trozos de carne para destruir los organismos preexistentes y los coloco en un recipiente abierto. Al cabo de un tiempo observo colonias de microorganismos sobre la superficie y concluyo que se generaban espontáneamente a partir de la carne
-
Lázaro Spallanzani repitió el experimento pero tapando los recipientes, no apareciendo las colonias, lo que contradecía la teoría de lageneración espontánea. Pero Needham
argumento que el aire era esencial para la vida incluida la generación espontánea de microorganismos y este aire había sido excluido en los experimentos de Spallazani. -
Desarrollo empíricamente el método de tinción diferencial para bacteria que permite diferenciar dos tipos básicos de bacterias debido a su capacidad de retener (positivas) o (negativas) elcolorante básico cristal violeta (la diferencia entre los dos tipos básicos de bacterias se debe a la composición y estructura de la pared celular).
-
Franz Schuize pasó el aire a través de unas soluciones ácidas fuertes hacia el interior de un recipiente con carne hervida.
Los microorganismos habian sido aniquilados debido a estas soluciones acidas -
Theodor Schwann paso el aire a través de tubos calientes. Los microorganismos no aparecían ya que los microorganismos presentes en el aire habían sido aniquilados.
-
El experimento mas contundente de Pasteur
y que derrumbo la teoría de la generación espontánea, fue el de los “frascos con cuello de cisnes ” (frascos de Pasteur ). -
Louis Pasteur Investigó la PEBRINA gusano de seda que se enfermaba por protozoario, para eliminar enfermedades de los cultivadores, deben usar gusanos sanos para multiplicarlos.
-
Robert Koch presenta sus hallazgos el 24 de marzo de 1882 sobre el bacilo de la tuberculosis.
-
Robert Koch presenta su descubrimiento sobre el bacilo de la colera.
-
Louis Pasteur
-
Julius Richard Petri
-
Serguéi Vinogradski identificanda los géneros Nitrosomonas y Nitrosococcus, ambas oxidan amonio a nitrito, y Nitrobacter, que oxida nitrito a nitrato.
-
Reconoció la dependencia de las células virales para la reproducción
-
Demuestra que los mosquitos llevan el agente de fiebre amarilla.
-
Con la facilidad para el aislamiento de microorganismos y su cultivo enforma pura, se pudo iniciar el estudio de su comportamiento fisiológico.
-
Alexander Fleming en 1928 debido a un accidente d laboratorio descubre los hongos a los que llamaria Penicillium.
-
Aparición de la genetica microbiana
-
Probó la relación entre los genes y las enzimas al encontrar mutantes auxotroficos.
-
Max Delbruck y Salvatore Luria encontraron mutaciones espontáneas en bacterias.
-
Probaron contundentemente que el DNA era la molécula hereditaria y que las bacterias podían transferir genes mediante la transformación.
-
Demostraron que algunas bacterias también podían transferir genes mediante contacto célula (conjugación).
-
Francis Crick y James D. Watson. fueron los dos descubridores de la estructura molecular del ADN
Looking for a timeline maker?
Create timelines for projects, roadmaps, history, lessons, legal cases, and stories with Timetoast. Timetoast is a timeline maker for work, school, research, and stories.